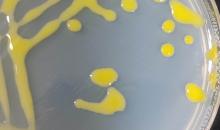

Clavibacter michiganensis(CORBMI)
Photos
For publication in journals, books or magazines, permission should be obtained from the original photographers with a copy to EPPO.

Appearance of cultures of six representative colonies of C. michiganensis subsp. michiganensis showing variation in colony morphology after 3 days of incubation at 28°C on YPGA. Colonies become deeper yellow, opaque and glistening with longer incubation
Courtesy: Harrie Koenraadt, Naktuinbouw, NL
Pure culture and single colonies of yellow-pigmented variant of C. michiganensis streaked on YPGA medium.
Courtesy: Ebrahim Osdaghi
Colonies of pink-pigmented strain of Clavibacter michiganensis on YPGA medium resulted from streaking of the water suspension of infected tomato leaves 96 h post incubation.
Courtesy: Ebrahim Osdaghi
Colonies of yellow-pigmented strain of Clavibacter michiganensis on YPGA medium resulted from streaking of the water suspension of infected tomato leaves 96 h post incubation.
Courtesy: Ebrahim Osdaghi
Pure culture and single colonies of pink-pigmented variant of C. michiganensis streaked on YPGA medium.
Courtesy: Ebrahim Osdaghi
Symptoms of the bacterial canker of tomato caused in the interior part of ripening fruit. Discoloration of placenta from white to deep yellow indicates the infection
Courtesy: Ebrahim Osdaghi
Typical symptoms (extended canker on stem) of the bacterial canker of tomato in the final stages of infection leading to plant death
Courtesy: Ebrahim Osdaghi
Typical symptoms (extended canker on stem) of the bacterial canker of tomato in the earlier stages of infection
Courtesy: Ebrahim Osdaghi
Severe infection of tomato plants with the bacterial canker pathogen leading to overall wilting and plant death
Courtesy: Ebrahim Osdaghi
Detection of C.m. michiganensis from seed samples with Pastrik PCR.
Courtesy: J. van Vaerenbergh, ILVO-DCP, Merelbeke (BE).
Local infection on sweet pepper leaf in nursery.
Courtesy: J. van Vaerenbergh, ILVO-DCP, Merelbeke (BE).
Detection of C. m. subsp. michiganensis in seed samples with Dreier PCR.
Courtesy: J. van Vaerenbergh, ILVO-DCP, Merelbeke (BE).
Symptoms of bacterial canker (C. michiganensis subsp. michiganensis) on a tomato plant.
Courtesy: Heinz USA (US).
Wilted tomato plants 2 weeks after inoculation with C. michiganensis subsp. michiganensis.
Courtesy: Heinz USA (US).
Infected vascular stem tissues with mealy appearance of vascular parenchyma.
Courtesy: J. van Vaerenbergh, ILVO-DCP, Merelbeke (BE).
Clavibacter michiganensis subsp. michiganensis on NGA.
Courtesy: J. van Vaerenbergh, ILVO-DCP, Merelbeke (BE).
Clavibacter michiganensis subsp. michiganensis on NGA.
Courtesy: J. van Vaerenbergh, ILVO-DCP, Merelbeke (BE).
White dessicated leaf areas giving the tomato plant a sunburned appearance.
Courtesy: J. van Vaerenbergh, ILVO-DCP, Merelbeke (BE).













